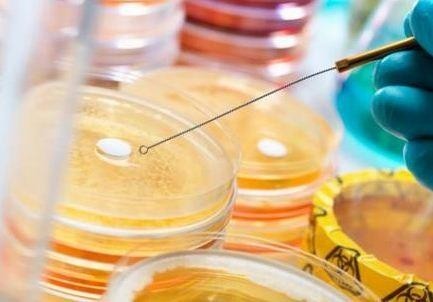
碘伏(液体)

万千商家帮你免费找货
0 人在求购买到急需产品
- 详细信息
- 询价记录
- 技术资料
- 保存条件:
常温
- 保质期:
2年
- 英文名:
详见
- 库存:
37
- 供应商:
上海梵态生物科技有限公司
- 规格:
250g/500g
| 规格: | 250g | 产品价格: | 询价 |
|---|---|---|---|
| 规格: | 500g | 产品价格: | ¥100.0 |

规格:250g/瓶
保存条件:常温
培养基的成分: 培养基的成分主要为水、无机盐、有机物、天然复合物、培养体的支持材料等五大类。有的培养基还含有抗菌素、色素、激素和血清。
培养基按其物理状态可分为固体培养基、液体培养基和半固体培养基三类。
(1)固体培养基。是在培养基中加入凝固剂,有琼脂、明胶、硅胶等。固体培养基常用于微生物分离、鉴定、计数和菌种保存等方面。
用于微生物分离,鉴定,计数。如图,微生物分离成菌落、菌苔。图中为大肠杆菌菌落,是用涂布平板法得到。
用于分离微生物的固体培养基
用于分离微生物的固体培养基
(2)半固体培养基。是在液体培养基中加入少量凝固剂而呈半固体状态。可用于观察细菌的运动、鉴定菌种和测定噬菌体的效价等方面。
用于观察微生物运动特征。如图,左侧试管中微生物不运动,而右侧试管中微生物运动,因而两试管中现象不同
用于观察微生物运动特征的半固体培养基
用于观察微生物运动特征的半固体培养基
(3)液体培养基。液体培养基中不加任何凝固剂。这种培养基的成分均匀,微生物能充分接触和利用培养基中的养料,适于作生理等研究,由于发酵率高,操作方便,
碘伏(液体)
请佩戴口罩操作,以避免因培养基粉尘而引起呼吸道系统不适。
干粉培养基容易吸潮结块,使用后应立即旋紧瓶盖。
平板厚度过薄容易造成琼脂水分保持性下降,开裂,自制平板时需注意培养基的厚度;15-20mL(Φ90mm)体积培养基,平板培养基厚度至少为2mm。
储存条件及保质期→脱水干粉培养基的贮存期一般为二年,需贮存于避光和阴凉干燥的环境之下,使用后请立即旋紧瓶盖。
废物处置→检测之后带菌平板置于121℃下高压灭菌30分钟。
碘伏(液体) 相关产品:1,全:公司提供上万种产品,涵盖了生物试剂,elisa试剂盒,标准品,培养基,原装耗材等,基本上各种科研所需产品在我司都能找到。
相关产品:1,全:公司提供上万种产品,涵盖了生物试剂,elisa试剂盒,标准品,培养基,原装耗材等,基本上各种科研所需产品在我司都能找到。
2,新:产品更新速度较快,基本上每周都有新产品出现。
3,优:产品质量好,零投诉。
4,品牌多:公司代理的试剂品牌:Amresco、Sigma、Fluka、Alfa、TCI、Merck等进口品牌,国产品牌我们价格更优,我们供应优级纯,分析纯,化学纯,试剂级,基准试剂,实验纯,教学试剂,高纯试剂,色谱纯,光谱纯,电子纯等试剂级别(可根据客户需求定制)。
5,售后:我公司具有优质的技术团队,产品一旦售出,产品仅用于科研实验过程中遇到困难可提供在线技术咨询。使您使用产品时没有任何的后顾之忧。
风险提示:丁香通仅作为第三方平台,为商家信息发布提供平台空间。用户咨询产品时请注意保护个人信息及财产安全,合理判断,谨慎选购商品,商家和用户对交易行为负责。对于医疗器械类产品,请先查证核实企业经营资质和医疗器械产品注册证情况。
- 作者
- 内容
- 询问日期
 技术资料
技术资料暂无技术资料 索取技术资料





